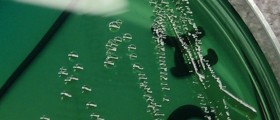
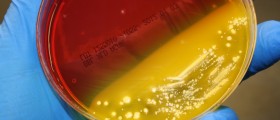

Introduction and General Information on Salmonella
Salmonella infection is a bacterial infection. The illness affects gastrointestinal tract. This bacterium is normally present in gastrointestinal tract of animals. In humans it is present in stool of chronic carriers of the disease. Animals such as poultry can transmit the infection onto the eggs which are then the source of bacteria. If humans eat contamined food (meat, eggs etc.) which is not thermally treated and is raw they will most probably get the infection.
The symptoms include diarrhea with severe cramps. Vomiting and nausea are present as well. The infection lasts approximately 7 days. The treatment in majority of patients is not necessary. Only those who are dehydrated need to be given intravenous fluids. Still there are certain complications that may develop as a consequence of salmonella infection. People who are traveling to countries which present with inappropriate hygiene conditions put themselves at risk of getting salmonella poisoning.
Complication of Salmonella Infection
The simple infection with salmonella is not so dangerous. Still little children of elderly patient and those suffering from chronic conditions may be jeopardized with the infection.
Dehydration is most common complication of salmonella poisoning. It is caused by prolonged and severe vomiting and diarrhea. The fluids are lost more than they can be compensated. Signs and symptoms of dehydration include dryness of skin and visible mucous membranes, sunken eyes, decreased or no urination at all. The fluid is given orally if one may swallow and hold it in stomach. If this is not possible the intravenous fluids are applied.
The problems can also occur if the infection affects other organs apart from intestines. If salmonella gets into the bloodstream bacteriemia develops. These bacteria may reach every organ and lead to further complications. If it affects brain and brain membranes the meningitis occurs. Endocarditic develop as a consequence of the attack of these bacteria into their heart. If the bacteria reach bones it can cause osteomyelitis.
People who have suffered form salmonella poisoning are more prone to reactive arthritis. Reactive arthritis is also known as Reiter's syndrome. This autoimmune disease presents with irritation of the eyes, pain during urination, and pain in joints.
Prevention
Prevention is something which can be done in majority of cases. The food has to be prepared properly and should not be eaten raw. Hygiene has to be maintained adequately. One should wash his or her hands every time after going to toilet and before every kind of food manipulation and preparation.

_f_280x120.jpg)








Your thoughts on this
Loading...